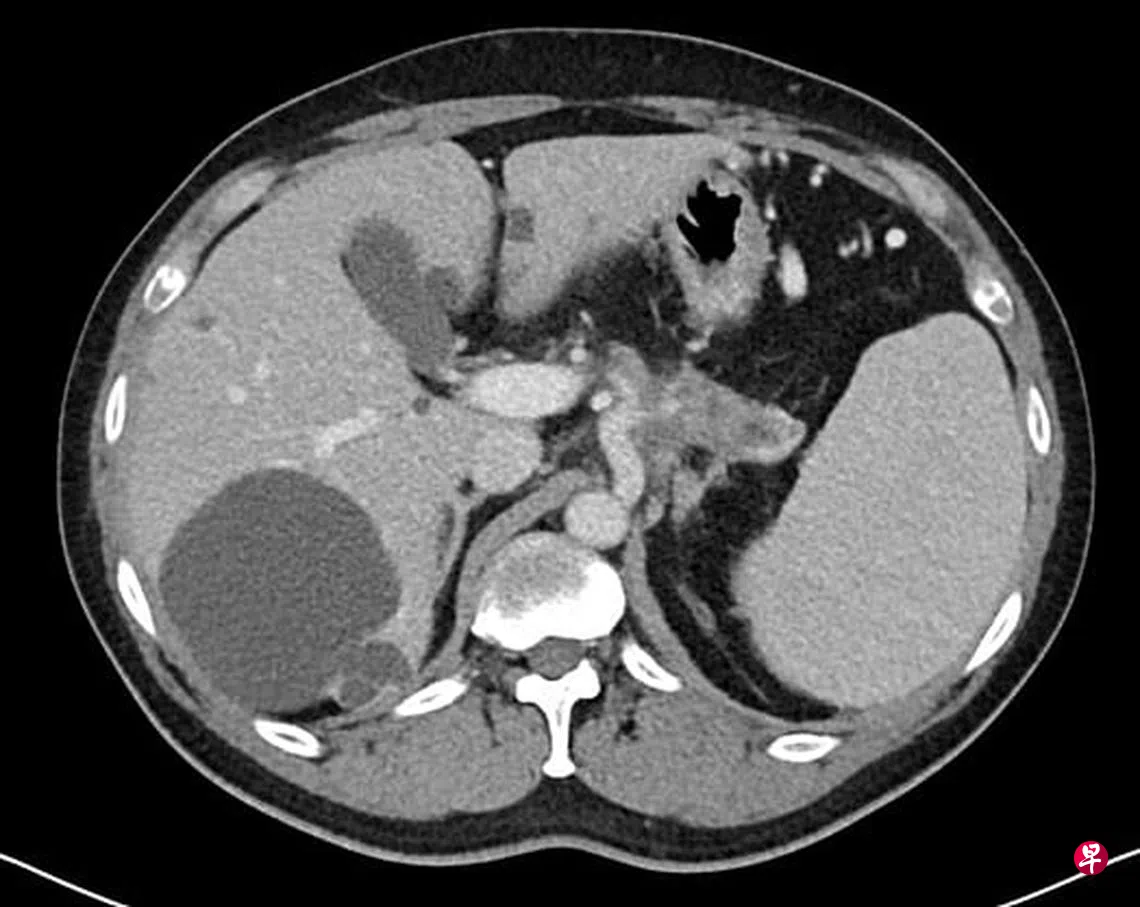

术后,利用化学药物来清理循环着的癌细胞、淋巴腺等,在早期的效果非常不理想。在悲观的同时,希望的曙光慢慢到来。
胰腺癌是许多癌症中脾性最为凶猛的肿瘤之一。目前,胰腺癌死亡率在全球癌症排名第七。根据世界卫生组织在国际癌症研究署(International Agency for Research on Cancer, WHO)2020年数据,胰腺癌发病的病人当中,男性较为常见,平均年龄为71岁以上。
在新加坡,胰腺癌的死亡率,男女排名为第五。胰腺癌是目前较为难以治愈的癌症,归咎于不同原因:其一、胰腺的所在位置是腹腔最为深入的部位,是胃脏的后面,在大动脉及脊髓的前面。如肿瘤长在胰腺头部,病人有可能因黄疸迹象(如尿液呈茶色、皮肤发黄、眼白发黄或粪便呈灰色等)而寻医。但是,若肿瘤长在胰腺体部及尾部,发现时大多都太迟了。由于所在位置非常深入,而且早期没有症状,肿瘤必须长到一定的程度,开始侵袭周边组织,方造成症状。所以,大多的胰腺癌当发现时已经晚了。